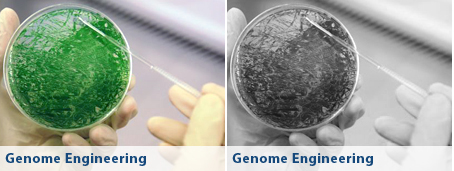
metabolic engineering

Our Science and Capabilities
SGI is built on pioneering science that has furthered biological knowledge. From rapidly discovering genes and developing advances to sequence whole genomes, to making innovations in synthesizing and constructing whole chromosomes and genomes, Drs. Venter, Smith and their teams are trailblazers in the use and development of these disruptive technologies. Today, that legacy of pioneering basic science research leading to transformative applications continues. At SGI, our scientists have a wide array of expertise and apply their skills to the development of our core products. In short, our science is the platform upon which all of our commercial applications are built. Our scientific capabilities include: synthetic biology/genomics, environmental genomics, plant genomics, microbiology, bioinformatics, genome engineering, analytical chemistry, fuel chemistry, and biochemistry and assay development.